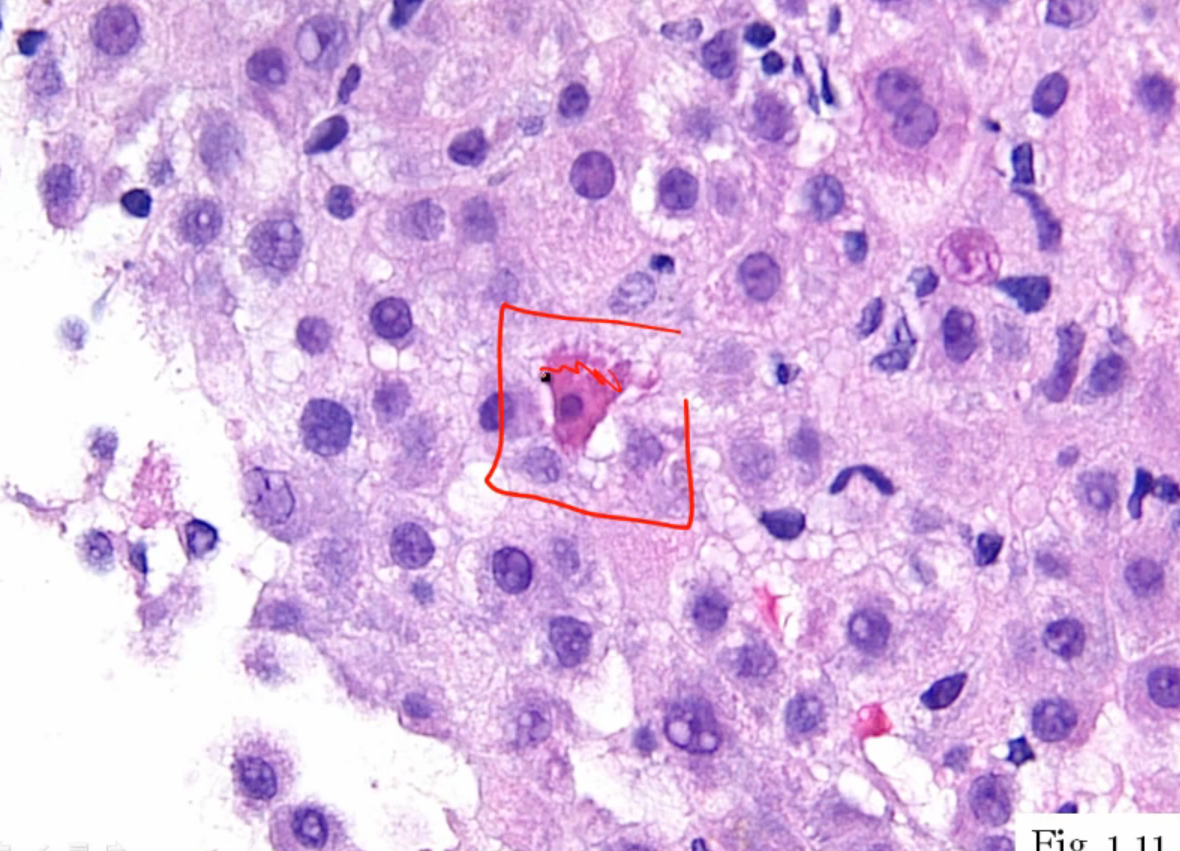

Explain the ‘sawtooth appearance’ on histology of lichen planus
Lichen planus = inflammation (neutrophil infiltration) at the epidermal-dermal junction that gives a saw-tooth appearance of the basement membrane

Which cancer is associated w/ ‘starry sky’ appearance on histology

Buzzword: ‘starry sky’ = Burkitt Lymphoma = neoplasm of intermediate shaped B cells caused by c-myc translocation
These are hepatocytes- describe the changes

Fatty liver! Showing fat droplets inside hepatocytes
ex: CCL4 exposure, free radical production (CCL3 free radical) causes hepatocyte destruction = reduction in apolipoprotein production so fat gets trapped in the liver
Type of tissue necrosis seen in pancreatitis
Pancreatitis = when pancreatic enzymes get activated early, in the pancreatic parenchyma instead of in the lumen of the small intestines
Image showing both liquefactive (black stuff) and fat necrosis (chalky white)

Differentiate the 5 kinds of neoplasms that can arise from hematopoietic stem cells
5 neoplasms from the HSC –> myeloblasts and leukoblasts
Acute leukemia arises from neoplastic proliferation of blasts due to maturation defect
-

What are Anitschkow cells?
(a) Dx?
Anitschkow cells = histiocytes w/ squiggly nuclei giving them the name ‘catepillar cells’
Anitschkow cells are found in Ashoff bodies in the myocardium pathognomonic for acute rheumatic fever myocarditis

Hallmark histologic feature of basal cell carcinoma
Peripheral palisading of nuclei

Name the main histologic features of a granuloma
Granuloma = aggregate of epitheliod histocytes (meaning lots of cytoplasm so very pink)
Note that all histocytes contain their nuclei = noncaseating granuloma

Describe the histologic features of Polyarteritis Nodosa
Polyarteritis Nodosa = vasculitis of medium sized vessels
Histologically characterized by fibrinoid necrosis (see the ton of pink squiggled in the pic)

Explain the mechanism of O2 dependent killing of phagocytosed material
(a) Oxidative burst
(b) Which chemical kills the bacteria?
Overall O2-dependent killing = O2 used to make HOCl- (bleach), bleach then destroys the organism
(a) O2 –> O2- by NADPH oxidase = oxidative burst
(b) Then O2- –> H2O2 (by supraoxide dismutase), H2O2 –> HOCl- by MPO (myeloperoxidase)
- so need NADPH oxidase, SOB, and MPO (all 3 enzymes) for O2-dependent killing

What type of granuloma? Explain
Noncaseating = lack of central necrosis
Differentiate the three stages of nuclear loss during cell death

Starts w/ pyknosis (nuclear shrinkage), then karyorrhexis (nucleus breaks up), then karyolysis (little pieces are broken down into building blocks) and then nucleus gone!
Loss of nucleus = hallmark of cell death

Is this acute or chronic inflammation?

Two key features of acute inflammation = edema and neutrophils
(while lymphocytes, plasma cells, and fibrosis would be indicative of chronic inflammation)
Name the two mechanisms of destruction of material inside phagolysosome
(a) Which is more effective?
O2-dependent and O2-independent killing
O2 dependent killing uses NADPH oxidase for oxidative burst and creates HOCl- (bleach) to kill bacteria, O2 independent directly uses enzymes (lysozme) to kill
(a) O2-dependent is much more effective

Name 2 disorders that are due to defects in O2-dependent killing

O2 dependent killing: first rxn is oxidative burst:
O2 –> (NADPH oxidase) –> O2-
O2- –> H2O2
H2O2 –> (myeloperoxidase) –> HOCl-
Dx

Reed Sternberg (‘owl eye’ cells = multi-lobed nucleus w/ prominent nucleoi
Name the layers of the skin
Basement membrane separates dermis and episdermis

What type of necrosis is shown in the left pic (compared to normal tissue on right)?
(a) Mechanism
(b) Classic clinical example

On the left you see tissue that has preserved cell shape and structure (maintained architecture) but no nuclei
= Coagulative necrosis
(a) Maintain architecture by coagulation of cellular proteins (hence coagulative necrosis…)
(b) This is the type of necrosis that happens 2/2 ischemic infarction of any tissue EXCEPT brain
Free radicals
(a) Name the 3 free radicals produced by partial O2 reduction
(b) Name the rxn by which free Fe produced free radicals
Free radicals are physiologically produced during oxidative phosphorylation if O2 doesn’t get all 4 electrons (so gets partially reduced)
(a) O2 –> O2- (superoxide) –> H2O2 (hydrogen peroxide) –> OH- (hydroxyl free radical) –> H20
- glutathione peroxidase is key free radical containing enzyme that catalyzes OH- to water
(b) Fentin rxn = Fe creates free radical

What type of necrosis is indicated by this picture?
(a) Most likely mechanism

Coagulative necrosis 2/2 ischemic infarct- see wedge-shaped pale area of infarction
(a) Ischemic infarct of any tissue besides the brain causes coagulative necrosis
- wedge shaped b/c of the way vessels branch (so obstruction at tip of the wedge causes necrosis in a wedge shape pattern outwards)
Type of necrosis shown in pic
(a) 2 mechanisms of this necrosis

Fibrinoid necrosis = necrotic damage to blood vessel wall
Name the two histological features used to diagnose amyloidosis on fat pad biopsy

What is the highlighted cell significant for?
Cell is undergoing apoptosis
Histologic feature of chronic cholecystitis
Chronic GB inflammation causes formation of Rokitasky-Aschoff sinuses = pseudodiverticula, basically inpouchings/pockets in the GB wall
-not dagernous on their own, but can indicate chronic cholecystitis
